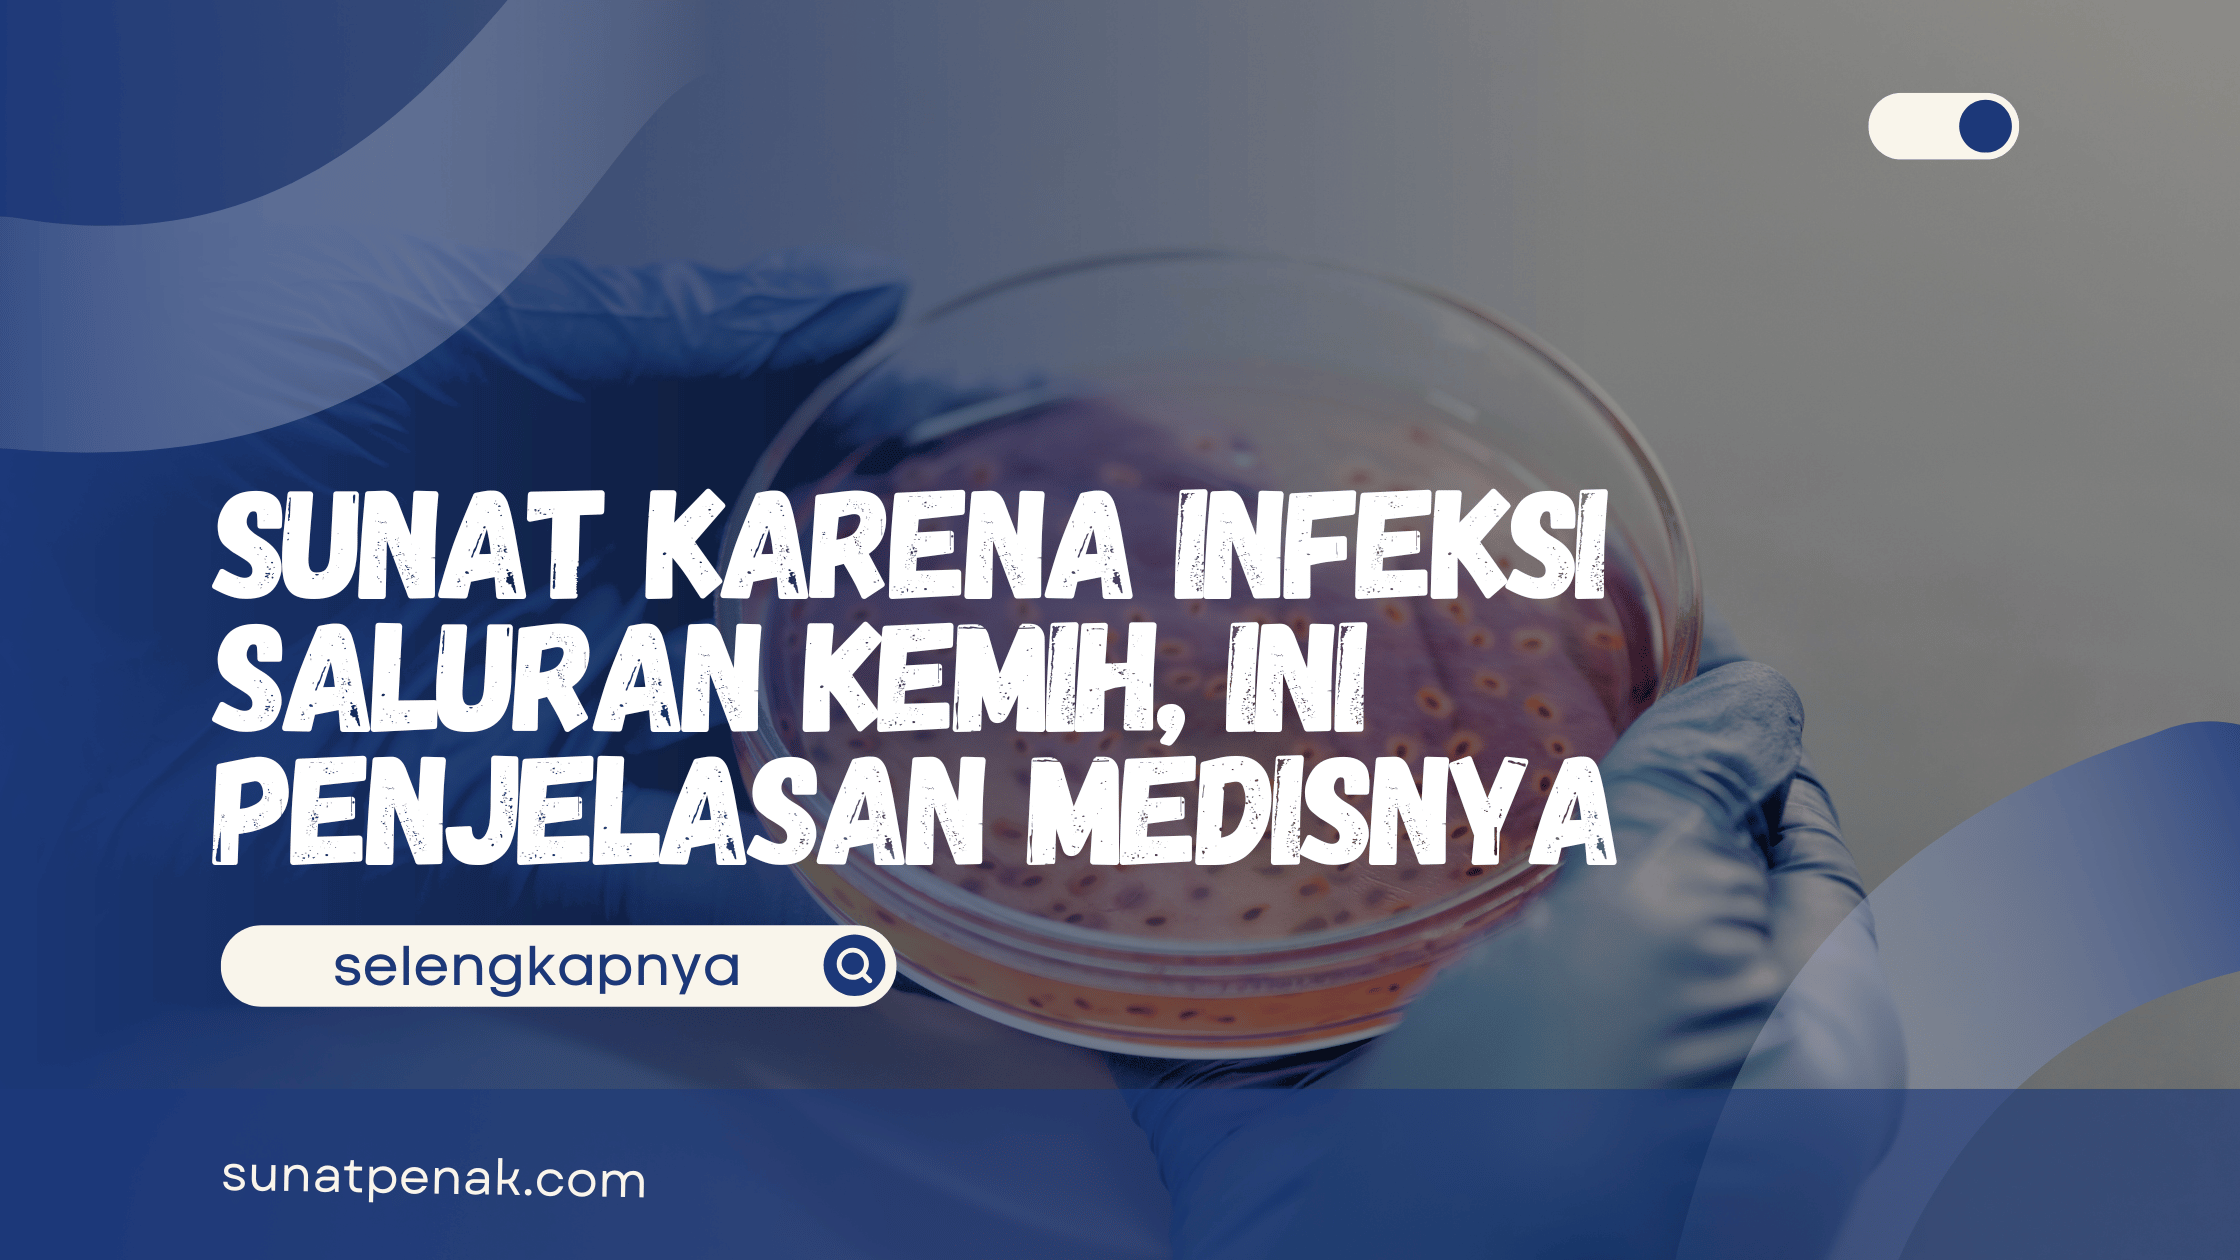
Sunat Karena Infeksi Saluran Kemih

Demam Setelah Khitan – Penyebab dan Cara Mengatasinya
Sunatpenak.com – Demam setelah khitan apakah wajar dan normal? Ayah Bunda pasti tahu bahwa khitan adalah momen penting dalam kehidupan anak laki-laki. Setelah prosedur sunat, sebagian kecil anak memang ada yang mengalami kenaikan suhu tubuh. Suhu tubuh anak yang sedikit naik setelah khitan bukanlah hal yang aneh ya Ayah Bunda. Tubuh